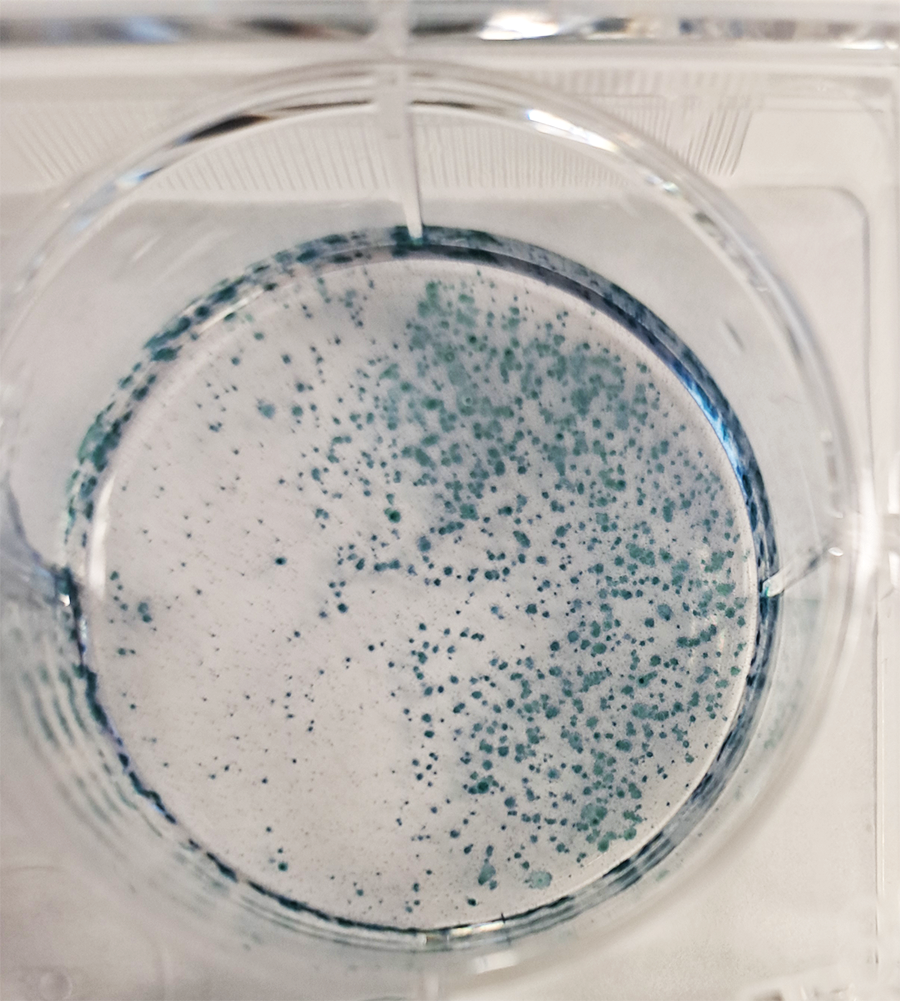

INCOGNITO™ iPSCMax™ Ψ-mRNA Reprogramming Mix

- Reprogram fibroblasts with an optimized, proprietary mix of five pseudouridine (Ψ)-containing, dsRNA-depleted mRNAs.
- Ultra-low immunogenicity Ψ-mRNA mix effectively avoids recognition by cellular innate immune response systems.
- Reprogram fibroblasts with as few as five transfections and get colonies within two weeks.
- Have peace of mind and save on downstream QC knowing no residual vector remains after reprogramming.
Product is for research use only (RUO)
Use and Label Licenses for Specific Products: Purchaser receives a
limited non-exclusive, non-transferable right to use the Products
purchased from CELLSCRIPT™ solely for its own internal laboratory
research use. See the Label License tab for more information. Click here for more information
Product Description:
The INCOGNITO™ iPSCMax™ Ψ-mRNA Reprogramming Mix contains an
optimized, proprietary mix of five pseudouridine (Ψ)-containing,
double-stranded RNA (dsRNA)-depleted mRNAs encoding proteins with the
ability to reprogram somatic cells, specifically fibroblasts, into
induced pluripotent stem cells (iPSCs) with high efficiency. INCOGNITO™
mRNAs contain the uridine analog pseudouridine which is substituted for
all uridines in the mRNA sequences. This substitution combined with
dsRNA removal using the Min-Immune™ Gold dsRNA Removal system
produces a mRNA mix with ultra-low immunogenicity that effectively
avoids recognition by the receptors of the cellular innate immune
response system.
The INCOGNITO™ iPSCMax™ Ψ-mRNA Reprogramming Mix is highly efficient,
requiring as few as five transfections and producing colonies within
two weeks. Due to the transient nature of mRNA in cells, INCOGNITO™
mRNAs leave no residual vector after reprogramming and pose no risk of
genomic integration of the exogeneous factors, reducing downstream
quality testing.
The Reprogramming Mix is available to reprogram either 6 wells (Cat.
No. IPY250906) or 12 wells (Cat. No. 2xIPY250906) of a 6-well plate.
Cells reprogrammed into iPSCs can be differentiated into multiple
cell types including neurons, cardiomyocytes and pancreatic islet cells
and can be a source of cells for use in basic science studies, drug
safety screening, development of immunotherapies and regenerative
medicine therapies.
Product Performance:

Figure 1. INCOGNITO™ iPSCMax™ Reprogramming Timeline.
Cells are reprogrammed into iPSCs with as few as five daily
transfections, generating colonies within two weeks.
Figure 2. Alkaline Phosphatase staining of iPSC
colonies in a well of fibroblasts reprogrammed using the INCOGNITO™
iPSCMax™ Ψ-mRNA Reprogramming Mix. The Reprogramming Mix results in high efficiency reprogramming producing colonies within two weeks.

Figure 3. Cells reprogrammed using the INCOGNITO™ iPSCMax™ Ψ-mRNA Reprogramming Mix stained positive for several pluripotency markers.

Figure 4. Cells reprogrammed using the INCOGNITO™
iPSCMax™ Ψ-mRNA Reprogramming Mix differentiated into the three germ
layers and stained positive for markers of each respective germ layer.
Product Resources
→ Manual
→ SDS
→ Product Flyer
Kit Contents
Materials Supplied:
Important Store at -70°C in a freezer without a defrost cycle. Do not store at -20°C.
Materials Required, but not Supplied
|
Product |
Vendor |
Catalog Number |
|
Adult Dermal Fibroblasts |
Supplied by user |
|
|
Primary Fibroblast Medium* |
ATCC® |
PCS-201-030 (Basal Medium) PCS-201-041 (Low serum fibroblast growth kit) |
|
Costar® Delta 6-well Tissue Culture Treated Plates |
Corning® |
3516 |
|
Trypsin-EDTA (0.5%), no Phenol Red |
Thermo Fisher Scientific® |
15400054 |
|
DPBS, no Calcium, no Magnesium |
Thermo Fisher Scientific |
14190144 |
|
DPBS with Calcium, with Magnesium |
Thermo Fisher Scientific |
14040133 |
|
Opti-MEM® I Reduced Serum Media |
Thermo Fisher Scientific |
31985062 |
|
Lipofectamine™ MessengerMAX™** |
Thermo Fisher Scientific |
LMRNA003 |
|
Laminin-521 Surface Substrate (LN-521™)*** |
Biolamina® |
LN521-02 |
|
ReproTeSR™ Reprogramming Medium |
STEMCELL™ Technologies |
05926 |
|
mTeSR® Plus iPSC Maintenance Medium |
STEMCELL Technologies |
100-0276 |
|
Y-27632 Rho/ROCK Pathway Inhibitor |
STEMCELL Technologies |
72304 |
*
Fibroblasts may be grown and expanded in any appropriate fibroblast
growth/maintenance medium. The fibroblast medium available through ATCC
is one suggestion.
**
IMPORTANT: This protocol has been optimized using the Lipofectamine
MessengerMAX transfection reagent. It is strongly recommended that this
reagent be used for transfection without substitution.
*** Other substrates may also be used to coat plates for reprogramming including Matrigel®, Vitronectin XF™, and CELLstart™ substrates.
LIMITED LABEL LICENSE
CELLSCRIPT™’s INCOGNITO™ iPSCMax™ Ψ-mRNA Reprogramming Mix (“Product”) is for rapid and efficient induction of induced pluripotent stem cells (iPSCs) from ex vivo
human or mammalian fibroblasts. This Product and the compositions,
kits, systems, methods and/or uses thereof are covered by WIPO PCT
Patent Application Numbers WO2007024708A2 and WO2011071931A2 and U.S.
Patent Numbers US8278036B2 and US9750824B2, and U.S. and international
divisional, continuation, or other patents and patent applications
derived therefrom that are owned by the University of Pennsylvania and
licensed to CELLSCRIPT™, and by U.S Patent Number US 9,580,689 B2, which
is exclusively licensed to CELLSCRIPT™ by the University of Minnesota.
By purchasing Product from CELLSCRIPT™ or an authorized distributor of CELLSCRIPT™ (herein, “Purchaser”), Purchaser receives a limited non-exclusive, non-transferable, non-sublicensable right (“Limited License”) to use the purchased Product solely to generate iPSCs from ex vivo human fibroblast cells for its own internal laboratory research use (the “Licensed Use”)
and Purchaser agrees to cite the name of the Product and CELLSCRIPT™ as
its source in any verbal or written public disclosure about said
Licensed Use. The Licensed Use expressly excludes using Product
for any Commercial Use or for making any product for Commercial Use,
including: [A] for any diagnostic, prophylactic, clinical, therapeutic or other use in humans, [B] for any veterinary, livestock, or agricultural use in animals, [C] for generating human iPSCs, hematopoietic stem or progenitor cells, neurons, immune cells or any other cells, and/or [D] for
the manufacture, distribution, importation, exportation, or sale of
products and/or services made using Product for which Purchaser receives
compensation of any kind, it being understood that [A]–[D] are separately and/or collectively defined as a “Commercial Use” herein.
No license rights are granted, expressly or implied, to make, have
made, import, export, use, reverse engineer, transfer, offer for sale,
or sell Product, derivatives of Product, or services using Product for a
Commercial Use. By purchasing Product, Purchaser agrees not to make,
have made, import, export, use, reverse engineer, transfer, offer for
sale, or sell Product, components of Product, or derivatives of Product,
or to provide services, or to generate information, data, compositions,
methods, applications, or uses thereof in exchange for money or any
other consideration, and Purchaser agrees not to use Product, components
of Product, or derivatives of Product to support filing of a patent
application in any country or other patent office in the world unless
otherwise agreed by CELLSCRIPT™ in writing prior to such use.
CELLSCRIPT™ provides no warranties (statutory or implied) concerning
merchantability or fitness of Product for a particular use and does not
represent or warrant that Purchaser’s use of Product will not infringe
patent or other intellectual property rights of any other party, and all
such warranties of non-infringement are expressly disclaimed. This
Limited License terminates automatically if Purchaser breaches any of
the terms herein.
This Limited License remains in effect if Product is being used in
accordance with the license terms. The license is terminated
immediately upon user’s breach of any of the license terms, such as
using the product for commercial purposes without proper authorization.
If your organization is interested in using INCOGNITO™ iPSCMax™ Ψ-mRNA Reprogramming Mix or any other CELLSCRIPT™ products for a Commercial Use, whether in catalog or custom sizes, please contact us with a description of your interest and needs.
If you cannot find the answer to your problem then please contact us or telephone +44 (0)1954 210 200